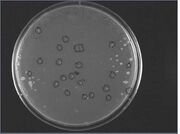

Uploads by Sambu
From OpenWetWare
Jump to navigationJump to search
This special page shows all uploaded files.
| Date | Name | Thumbnail | Size | Description |
|---|---|---|---|---|
| 17:43, 14 October 2007 | Harvardigem07finalppt v13.ppt (file) | 3.54 MB | ||
| 00:40, 12 October 2007 | Harvardigem07finalppt v8.ppt (file) | 3.39 MB | ||
| 00:35, 12 October 2007 | Targeting slides.ppt (file) | 854 KB | ||
| 05:12, 16 September 2007 | SlideCollectionEdit2.ppt (file) | 150 KB | ||
| 03:55, 16 September 2007 | Slide Collection edit 2.ppt (file) | 93 KB | ||
| 03:35, 16 September 2007 | Slide Collection edit2.ppt (file) | 1.51 MB | ||
| 22:21, 24 August 2007 | Sammy Stocks filled.xls (file) | 33 KB | ||
| 13:58, 22 August 2007 | Slide Collection.ppt (file) | 1.62 MB | ||
| 17:50, 10 August 2007 | OmpA pos.jpg (file) | |
16 KB | |
| 17:50, 10 August 2007 | OmpA neg.jpg (file) |  |
12 KB | |
| 14:41, 6 August 2007 | Cuts pcr part5 focus.jpg (file) |  |
19 KB | |
| 15:40, 30 July 2007 | New grp presentation.ppt (file) | 236 KB | ||
| 20:00, 13 July 2007 | Pcr results.jpg (file) |  |
27 KB | |
| 15:38, 9 July 2007 | 2007-07-06protGel1.jpg (file) |  |
23 KB | |
| 00:49, 9 July 2007 | 1 protGel Jul7.jpg (file) |  |
174 KB | |
| 18:28, 7 July 2007 | SeeBlue std.jpg (file) |  |
6 KB | |
| 17:30, 6 July 2007 | 2007-07-06protGel2.jpg (file) |  |
140 KB | |
| 00:55, 28 June 2007 | 2z last denaturation electrophoresis 27.jpg (file) |  |
137 KB | picture taken in trans UV using a UV-to-white-light converter base |